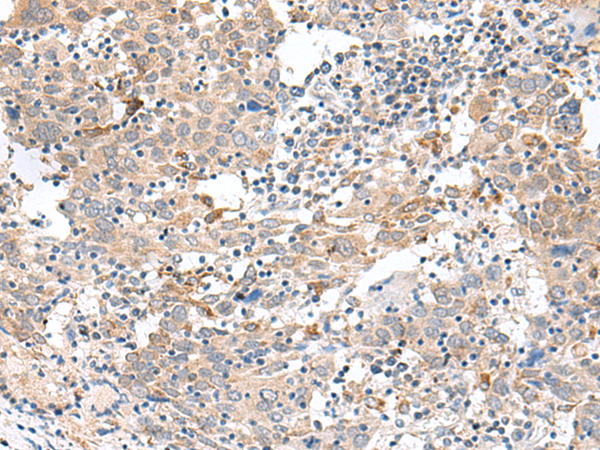

中文名稱:兔抗CCL8多克隆抗體
英文名稱: Anti-CCL8 rabbit polyclonal antibody
別 名: C-C motif chemokine ligand 8; HC14; MCP2; MCP-2; SCYA8; SCYA10
相關(guān)類別: 一抗
抗 原: CCL8
宿 主: Rabbit
克隆類型: rabbit polyclonal
技術(shù)規(guī)格
|
Background: |
This antimicrobial gene is one of several chemokine genes clustered on the q-arm of chromosome 17. Chemokines form a superfamily of secreted proteins involved in immunoregulatory and inflammatory processes. The superfamily is divided into four subfamilies based on the arrangement of N-terminal cysteine residues of the mature peptide. This chemokine is a member of the CC subfamily which is characterized by two adjacent cysteine residues. This cytokine displays chemotactic activity for monocytes, lymphocytes, basophils and eosinophils. By recruiting leukocytes to sites of inflammation this cytokine may contribute to tumor-associated leukocyte infiltration and to the antiviral state against HIV infection. |
|
Applications: |
ELISA, IHC |
|
Name of antibody: |
CCL8 |
|
Immunogen: |
Synthetic peptide of human CCL8 |
|
Full name: |
C-C motif chemokine ligand 8 |
|
Synonyms: |
HC14; MCP2; MCP-2; SCYA8; SCYA10 |
|
SwissProt: |
P80075 |
|
ELISA Recommended dilution: |
5000-10000 |
|
IHC positive control: |
Human cervical cancer |
|
IHC Recommend dilution: |
25-100 |
購物車
幫助
021-54845833/15800441009
